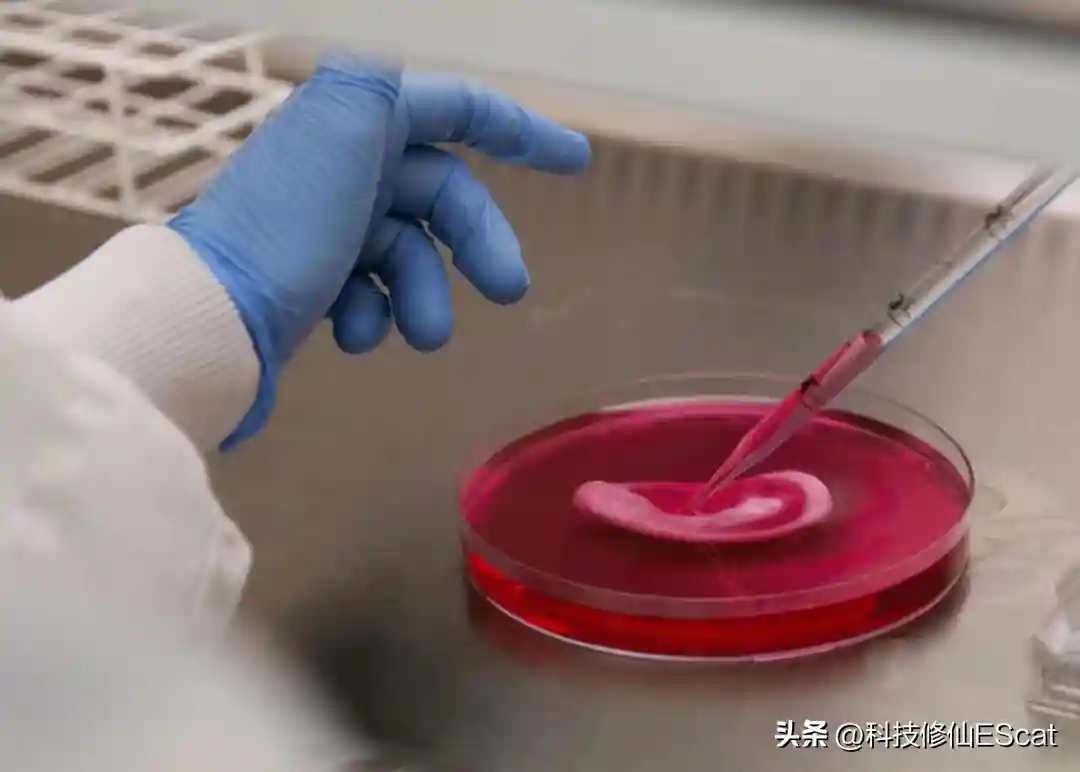

宇宙本身就是消极的,所有能量都遵循熵增定律,趋向于放射到黑暗中最后平均分布。但正是这样消极的宇宙,却诞生了对抗熵增的生命。

渺小的生命在毫无意义的物质世界随机产生,不断繁殖复制自己以求永生不灭,试图对抗宇宙最基本的熵增定律。由此看来,似乎繁衍就是生命唯一的使命。
例如蝴蝶的一生只有一周,交配产卵结束之后便立即迎来死亡;而像蜘蛛、螳螂,它们雄性在交配过程中就会被雌性吃掉。似乎他们自身生命的唯一意义,就是成为繁衍的牺牲品,人类也不例外!

人们在基因的操纵下相爱,结合,并利用生殖细胞供献出自己的一份染色体创造出新的生命。随后在留下自己的遗传物质后,结束潦草的一生。
然而想让孩子顺利诞生,也是一件极其困难的事情。孕育生命的过程不仅会对母体造成伤害,还要面对流产的风险。不过这样的无奈将会在未来消失。

因为根据近日发表在《细胞》杂志上的一项研究显示,以色列魏茨曼科学研究所的生物学家,在没有使用精子、卵子甚至子宫的情况下,仅通过干细胞和特殊的培养箱,就在实验室中培育出了小鼠胚胎模型。这是科学家创造出的,世界上第一个“合成胚胎”。

根据这份研究报告的描述可知,研究人员专门设计了一个生物反应器,用作胚胎发育的人造子宫。在该反应器内,胚胎漂浮在装有营养溶液的小烧杯内,这些烧杯又都被锁定在一个旋转的圆柱体中,使它们保持恒定运动。而这种运动是在模拟生物体内,血液和营养物质流向胎盘的场景。

上图:营养液中的合成胚胎样本

另外,该团队此前已在2021年使用这个生物反应器培养过了天然小鼠胚胎,证明了哺乳动物胚胎确实可以在子宫外生长。
而这次,他们为了绕过精子和卵子培育人工胚胎,选择先对小鼠干细胞进行了化学处理,将它们“重置”为幼稚状态。在这种状态下它们可以变形为任何类型的细胞,包括心脏、肝脏、大脑或其他细胞。

这些细胞被分成三组,其中一组含有会发育成胚胎器官的细胞,另外一组可发育成胎盘,还有一组可发育成卵黄囊。然后将三种类型的细胞在人造子宫中混合在一起,人工子宫会仔细控制压力和氧气交换,并轻轻移动烧杯以模拟自然养分的流动。
不出意外,这三种细胞很快聚集在一起形成团块,只是10,000个细胞团块中只有大约50个继续发育成胚胎样结构,且只在生物反应器中存活了8.5天。

上图:一个经过八天发育的合成胚胎
在这8.5天的过程中,中枢神经系统在第6天开始出现,很快就形成了一个皱巴巴的小脑。到第8天,胚胎已经发育出肠道和能够推动造血干细胞通过新形成的血管的跳动的小心脏。
这也意味着小鼠的干细胞已经可以自我组装成早期的胚胎样结构,具有肠道、大脑的雏形以及跳动的心脏。只是美中不足的是,它没有继续发育下去。可随着研究的进一步延伸,这是不是也意味着人工胚胎近在咫尺?

人工胚胎即将出现?
其实人工胚胎领域正在迅速发展,每年都有新的进展。例如2021年,就有几个团队设法让人类多能干细胞在培养皿中自我聚集,模仿“胚泡”。
这是胚胎发育的最早阶段,就在复杂的植入过程之前,当大量细胞附着在子宫壁上时。但这个过程在人类身上,比在老鼠身上更具挑战性。

并且,一些未参与此次研究的科学家认为,本次研究只是复刻了正常胚胎发育的某些方面,与天然胚胎的细胞结构和发育潜力,都存在较大差异。例如法国的胚胎干细胞学家LaurentDavid表示,他个人更愿称之为“胚状体”,即与胚胎相似的细胞簇。
因此可以肯定的是,要想将这一技术用于帮助人类生育,仍遥遥无期。然而总的来说,随着此项技术的进一步发展,最终应用在人类身上,势必会触及人伦道德的底线。

不过在可接受范围内,科学家或许可借此攻克诸如流产、不孕、先兆子痫等一系列尚未完全解决的早期生殖问题。
并且,通过对实验所用“机械子宫”的不断改进,有朝一日也许还可以作为细胞、组织、器官的孵化器。为成千上万等待移植手术的患者带来福音,挽救更多生命。
因此对人类胚胎研究的讨论,不能只有否定与排斥。随着科学技术的迅速发展,未来的世界是建立起一座座制造人类的工厂,还是解决人类器官移植与生殖保障的医疗机构,全在人类一念之间。而现在的咱们也是啥时候考虑,究竟该如何划清科学与道德的界限了!那么你是选道德,还是选科学?